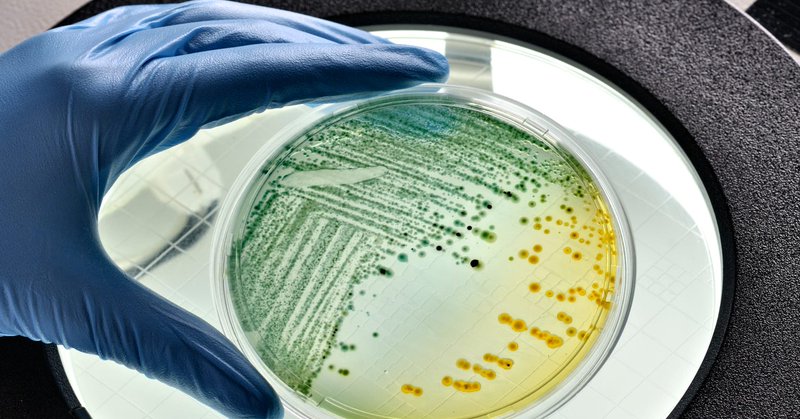
Tweet card summary image

Jen Fifield
@JenAFifield
Followers
33K
Following
10K
Media
3K
Statuses
23K
ProPublica reporter covering voting, elections and democracy. Former @votebeatUS @azcentral @stateline_news. Tips: DMs open and on Signal jenafifield.01.
Phoenix, AZ
Joined October 2011
I’m thrilled to announce that I’m joining ProPublica to cover voting issues nationally. I am so excited to work alongside some of the most skilled investigative journalists in the country at such a respected organization. I start Monday.
propublica.org
ProPublica is an independent, non-profit newsroom that produces investigative journalism in the public interest.
77
52
522
"If Indiana approves new congressional maps, it will cost at least $1 million to make the necessary changes ahead of the 2026 primary, Marion County's chief election officer says."
axios.com
Kate Sweeney Bell also estimates it will cost at least $1 million.
4
2
2
NEW: Arizona health officials withheld critical information about the source of an E. coli outbreak that sent multiple children to the hospital. — And now that it’s over, they say they there’s no reason to tell you. My investigation @azcentral ⬇️⬇️⬇️ https://t.co/lV6UygjK4L
azcentral.com
With no new cases emerging in at least two weeks, officials say the lack of an "ongoing risk" justifies the lack of information about what happened.
0
14
13
BREAKING: Texas can use its new, GOP friendly congressional map while a legal challenge plays out, the U.S. Supreme Court ruled, temporarily pausing a lower court ruling that had blocked the map from going into effect.
2
25
28
That would mean the general election ballot may have more of a far-R candidate and far-D candidate, along with an "Arizona Independent Party" candidate... Will be interesting to see how this goes. Read @CamrynSanchezAZ latest:
kjzz.org
A new lawsuit filed Tuesday seeks to void the name change of the Arizona Independent Party, arguing it will cause widespread voter confusion.
1
0
11
Full Self Driving Supervised drives like the best chauffeur imaginable Try it yourself at a nearby Tesla location
0
14
236
You're now a member of the Arizona Independent Party, which in AZ means you will can only get that party's ballot in the primary. This is key because it pulls independent-minded voters/moderates out of R & D primaries, maybe giving extreme candidates an advantage in primaries...
2
2
15
The fight over changing "No Labels Party" to "Arizona Independent Party" is important to pay attention to especially for Congressional races. If you're new to AZ, registering to vote and see "Arizona Independent Party" you might think it means you'll be unaffiliated but really...
13
33
72
Key: "The ... agreement is open-ended and doesn’t make clear whether the pledge to help Homeland Security obtain access to Nlets is limited to drivers from those four states or is intended to require the states to help the agency acquire the records of drivers nationwide."
0
0
1
Update: Indiana Senate Republican Mike Bohacek, who is a no on redistricting and had these stern words for President Donald Trump Friday, received a bomb threat later that evening, according to a statement. "This recent pattern of threatening behavior and intimidation attempts
New: Indiana Senate Republican Mike Bohacek, whose daughter has Down syndrome, says he’s a No on redistricting, citing Trump’s slur.
60
683
2K
Drivers in Florida, Indiana, Iowa and Ohio: DHS/USCIS is getting access to your driver's license records and data through this settlement.
4 Republican states will help Homeland Security obtain driver’s license records from @jonshorman and @stateline_news
https://t.co/pVfqWarINx
1
4
5
"I think that’s our superpower compared to national folks: We’re here, our kids go to the same schools, we go to the same sports games, we shop at the same grocery stores. When there’s an ice storm and your power goes out, our power goes out. We have skin in the game."
dailyyonder.com
Editor’s Note: This interview first appeared in Path Finders, an email newsletter from the Daily Yonder. Each week, Path Finders features a Q&A with a
2
20
59
Sleigh the season with the most personal gift around. Get them a Cameo video!
0
71
813
ICYMI: Unleash the lawyers: @AZCCEC votes to sue @Adrian_Fontes over letting No Labels Party rename itself as Arizona Independent Party. Now party officials say they will sue the commission. https://t.co/Bl0aQ7rZyz
4
3
7
Republican lawmakers are again looking to bar early ballot drop-offs on Election Day, and one proposal would gut the state's Active Early Voting List, though some details are vague.
axios.com
Republicans are seeking faster election results with an early ballot drop-off ban.
3
2
9
BREAKING: The case against Donald Trump in Georgia is officially dead. The prosecutor who took it over recently has moved to drop it – and Judge McAfee has granted the motion. https://t.co/8ozH636yaD
197
417
1K
DHS might try to get around states' refusal to provide driver's license data for citizenship checks by obtaining it from a nonprofit that collects it for local law enforcement purposes
stateline.org
The Trump administration wants access to state driver’s license data on millions of U.S. residents as it builds a powerful citizenship verification program amid its clampdown on voter fraud and...
2
7
13
Here is a companion piece with more new revelations from this trove of documents: https://t.co/6g4JaisTLh Among other things: - Jeanine Pirro asked the RNC to buy her book - Tucker Carlson called Trump "a total piece of shit" - Maria Bartiromo made $70 million. - Sean Hannity
theguardian.com
Tens of thousands of documents were released as part of Smartmatic’s defamation lawsuit against the network
1
92
230
BREAKING: Texas has formally petitioned the Supreme Court to restore its newly drawn congressional map, and Justice Samuel Alito has ordered a response to the petition by Monday at 5PM. Details TK.
44
249
682
BREAKING @AZAGMayes will keep 'fake electors' case alive with appeal to Arizona Supreme Court.
12news.com
Mayes asking Arizona Supreme Court to review lower court ruling that would have returned case to grand jury. Court had set Friday deadline for decision.
42
47
129
NEW: How the Trump Administration Abandoned Plans for a Major Cut in Disability Benefits for Older Workers https://t.co/y644Y4gISP by Eli Hager
propublica.org
After meeting with advocates, the Trump administration confirmed it has scrapped a controversial regulation that would have cut disability benefits for older workers.
0
3
3
I’m in downtown Lancaster where the county is about to do a “game of chance” drawing to determine the winner of a 26 way tied election. You might this is uncommon, but it’s not. We’ll have a story out later.
1
2
10
They called him the False Hero. Fearing what he would bring upon the world, they sentenced him to death. But he lived. And now they're going to learn. They were right to be afraid.
2
0
11
Fontes responds to increase in rejected ballots in Maricopa County
Arizona voters deserve access to every tool available to ensure they can track the status of their ballots and cure signature issues quickly. That’s why I have requested funds from the state legislature to continue providing TrackMyBallot and Text2Cure services to voters
4
0
11